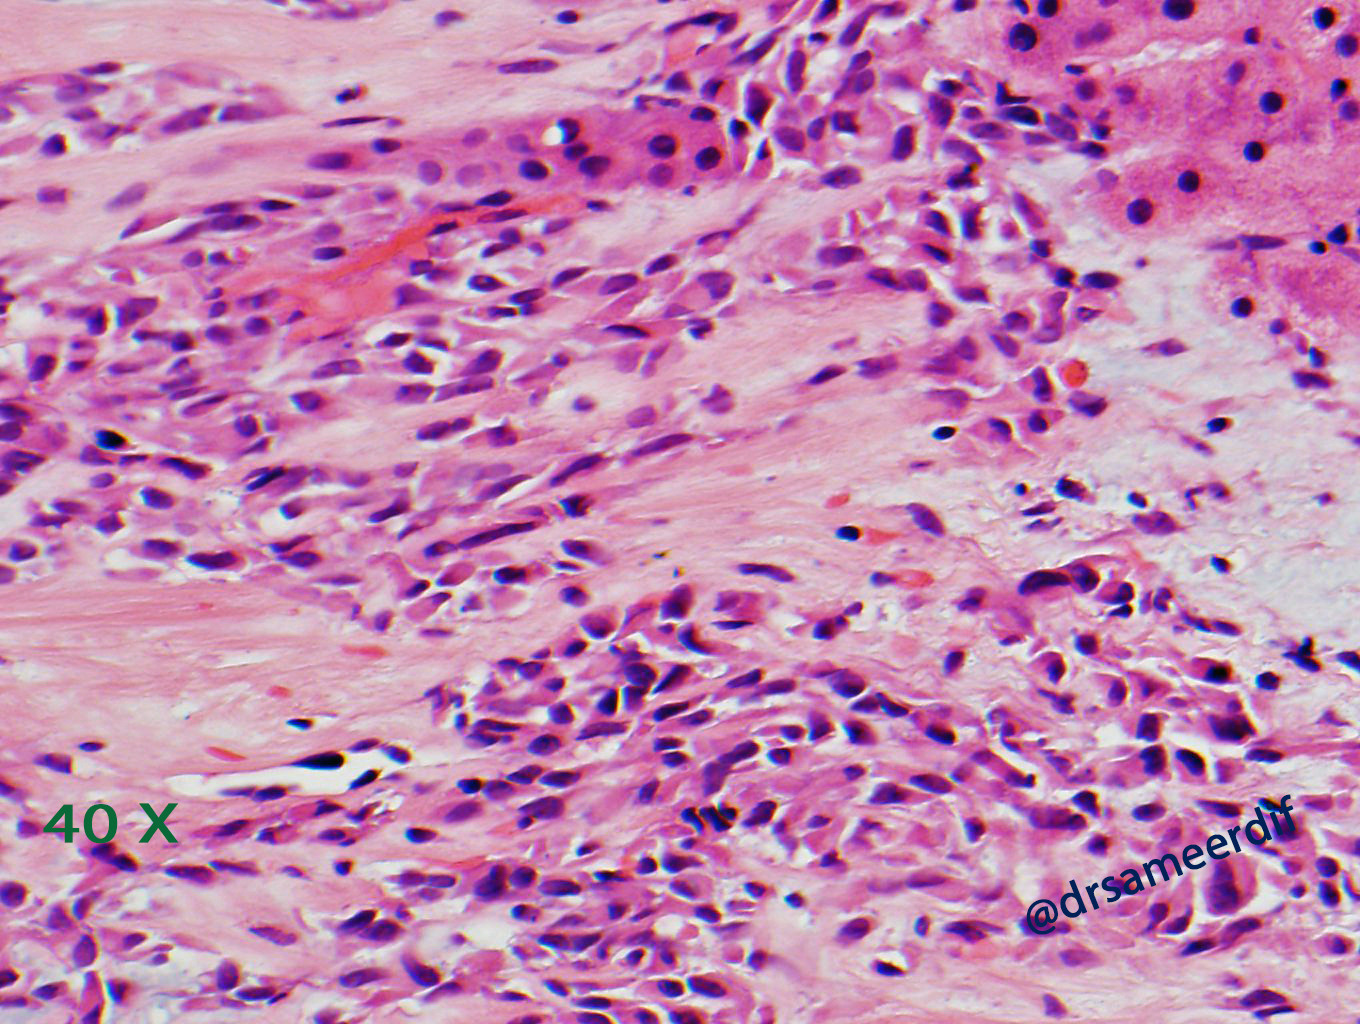
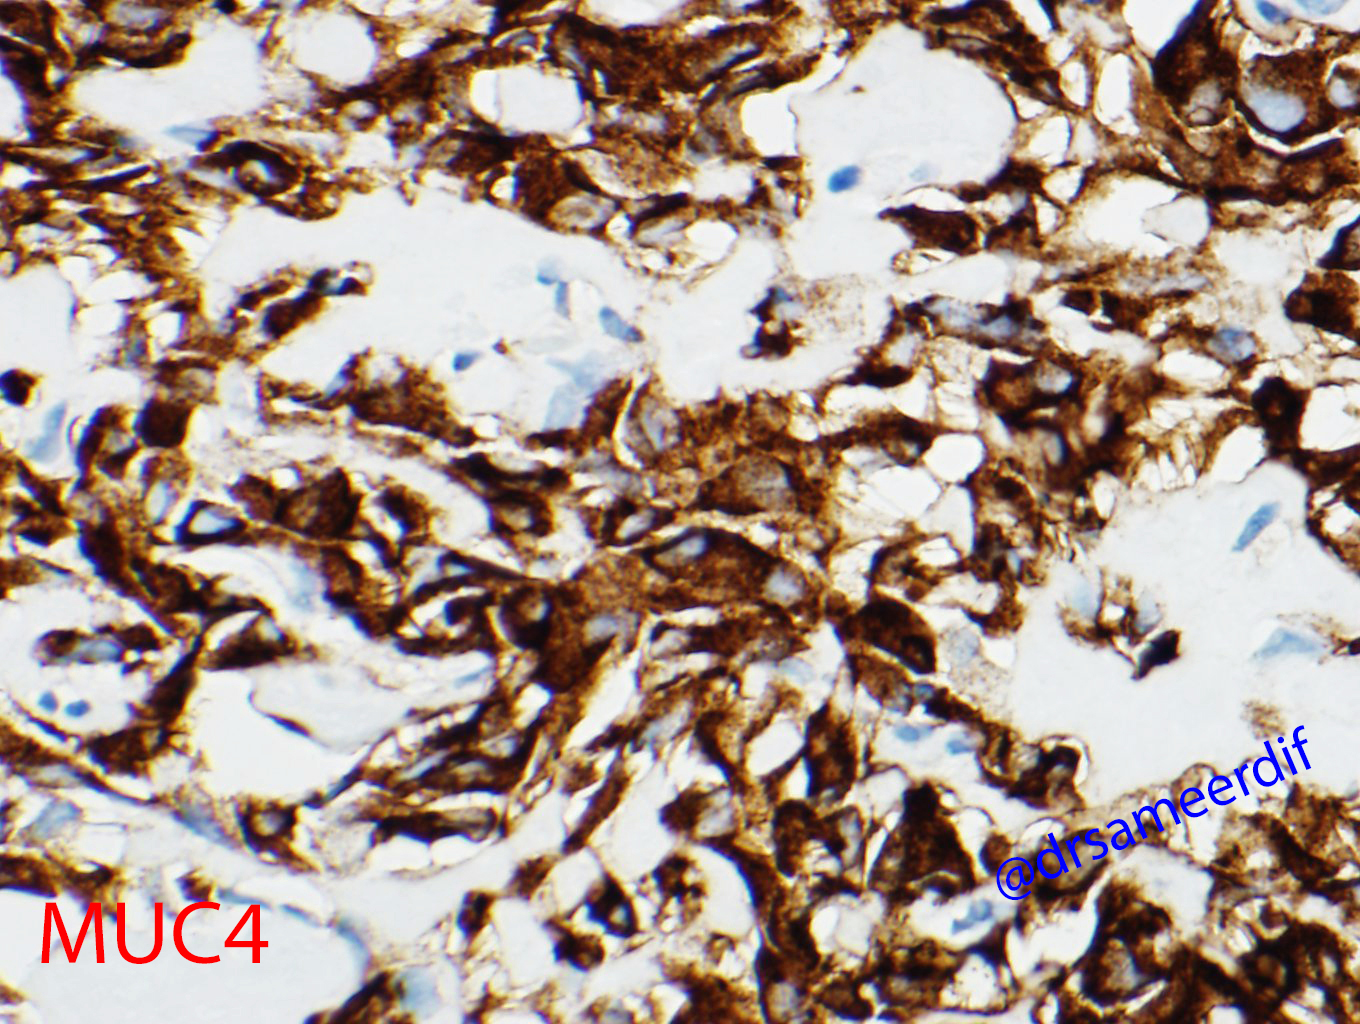

Case History

Answer is: C-Sclerosing epithelioid fibrosarcoma (SEF)
Discussion:
The current biopsy shows a densely hyalinized sclerotic matrix, with focal areas reminiscent of osteoid, lined by small to medium-sized epithelioid cells with clear to eosinophilic cytoplasm and bland nuclei. Mitotic figures are inconspicuous. By immunohistochemistry, the neoplastic cells are positive for MUC4, but negative for CK7, CK20, SATB2, and calcitonin. The morphology and immunohistochemical results are diagnostic of metastatic sclerosing epithelioid fibrosarcoma (SFE) from primary know SFE of the soft tissue.
SEF is a rare variant of fibrosarcoma that commonly occurs in soft tissue. The microscopic diagnostic criteria includes:
- Nests and cords of small to medium size, round- oval nuclei with scant clear to pale cytoplasm
- Hyalinized stroma, which may resemble osteoid. Sometimes cartilaginous and osseous metaplasia may be seen and it may show focal myxoid change or calcification.
- MUC4 positive
- EMA IHC positive in about half of the cases.
Since its original description in 1995 by Meis-Kindblom et al., studies have revealed cytogenetic similarities with low-grade fibromyxoid sarcoma (LGFMS) and hybrid tumor composed of SEF and LGFMS. SEF shares the t(7;16) that is characteristic of low grade fibromyxoid sarcoma. However, few case reports have shown that SEF harbors EWSR1 gene rearrangement which is distinct from the chromosomal abnormalities seen in LGFMS. Fluorescence in situ hybridization demonstrates split signals for the EWSR1 gene.
The ddifferential diagnosis for SEF includes:
- Low Grade Fibromyxoid Sarcoma: It has alternating fibrous and myxoid areas. The tumor cells are spindled and is usually positive for MUC4, However EMA is occasionally weak or focal.
- Carcinoma: The tumor cells are epithelial origin and usually positive for Pancytokeratin, CAM5.2 AE1/3 etc.